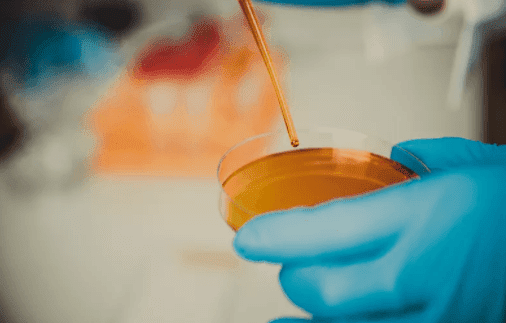
消泡劑應(yīng)用圖

- 歡迎來到廣東天峰消泡劑有限公司官方網(wǎng)站!
- 在線客服QQ 網(wǎng)站地圖 免費拿樣
-
 專研高品質(zhì)
專研高品質(zhì)消泡劑
不忘初心·只為消泡 -
消泡劑技術(shù)服務(wù)熱線:134-3367-8080
 一對一溝通消泡劑報價
一對一溝通消泡劑報價


現(xiàn)在不管是我們的工業(yè)生產(chǎn)制作還是我們的日常生活中,都會遇見泡沫,不同行業(yè)不同的泡沫帶來的問題也是不一樣的,受泡沫影響的程度也是不同的,泡沫的出現(xiàn)也就讓消泡劑行業(yè)在大家眼中出現(xiàn)的更加的頻繁了,但是它的種類居多,想要一款合適自己的消泡產(chǎn)品,往往都需要找到靠譜的消泡劑生產(chǎn)廠家
(消泡劑應(yīng)用圖)
天峰消泡劑廠家為了解決不同行業(yè)的泡沫問題,把消泡劑按照成分分為有機硅氧烷、聚醚、硅和醚接枝、含胺、亞胺和酰胺類的,按在形態(tài)又分為乳液液態(tài)型的以及固態(tài)粉末型的,并且按在它們的消泡環(huán)境又可以分為耐高溫性的以及耐酸堿性的,同時對于一些行業(yè)的特殊要求以及根據(jù)不同行業(yè)的起泡特性天峰廠家在這些消泡劑的原基礎(chǔ)上還做了一定的調(diào)整,比如在乳膠、粘合劑、紡織印染、發(fā)酵、涂料、水處理、石油、造紙等32行業(yè)進行消除有害的泡沫。
廣東天峰是一家專為解決不同泡沫問題而研發(fā)不同的消泡劑生產(chǎn)廠家,有著300平的獨立的研發(fā)室以及具有自己的現(xiàn)代化流水線生產(chǎn)車間,并且他們家的消泡產(chǎn)品可以滿足不同行業(yè)的消泡要求,并且根據(jù)行業(yè)要求都可以具有以下的優(yōu)點;
1.與起泡液具有一定的親和性,能良好的與起泡液相容,以及消泡迅速消泡能力強、抑泡時間久。
2.為了不與產(chǎn)品發(fā)生不良的化學(xué)反應(yīng),因此他們家的消泡產(chǎn)品具有良好的穩(wěn)定性以及生理惰性,從而避免出現(xiàn)消泡產(chǎn)品與其他的助劑發(fā)生反應(yīng),以及它影響產(chǎn)品質(zhì)量以及是生產(chǎn)工藝。
3.消泡產(chǎn)品是屬于濃縮型的,配方濃度較高,因此的它的使用添加量也少,在用量少的情況下也可以發(fā)揮出它優(yōu)異的性能。
靠譜的消泡劑生產(chǎn)廠家不止天峰,還是還有德豐、華盛源、中聯(lián)邦、天德等廠家,大家可以多方面考慮。天峰消泡劑生產(chǎn)廠家的消泡產(chǎn)品使用快捷方便,成本低、用量少、可以有效的幫助生產(chǎn)商解決泡沫的問題,并且改進生產(chǎn)流程、提高生產(chǎn)產(chǎn)品的質(zhì)量以及生產(chǎn)的工作效率。也正是因此天峰也受到了眾多的生產(chǎn)商的肯定



